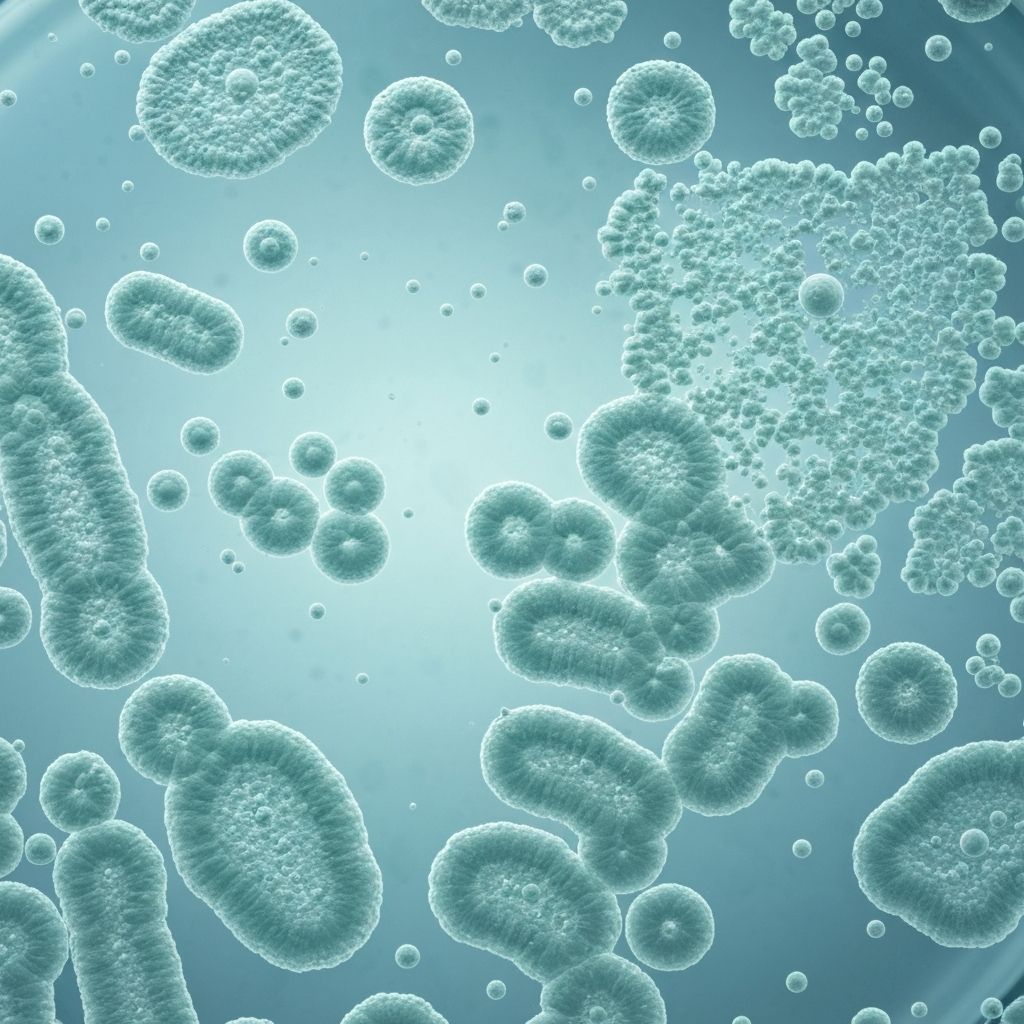
Microbiota science

The human gut microbiota represents a complex community of microorganisms inhabiting the gastrointestinal tract. Scientific literature describes this ecosystem as composed primarily of bacterial phyla, with Firmicutes and Bacteroidetes representing the dominant groups in most individuals. The microbiota performs numerous functions in host physiology, including the metabolism of dietary compounds, production of metabolites, and interaction with the immune system.
Understanding the general composition and diversity of the gut microbiota as described in observational research provides context for examining its potential associations with various physiological processes. Diversity—measured as the variety of microbial species present—is frequently noted in scientific literature as a characteristic that varies between individuals and may correlate with dietary patterns and other lifestyle factors.
Research typically describes the microbiota through molecular techniques that identify microbial taxa. These approaches have revealed significant individual variation in microbial composition, suggesting that no single "ideal" microbial profile exists across all individuals.